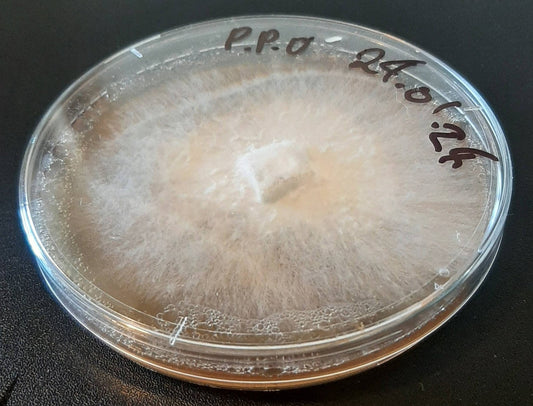

Grow guides

How to identify a mushroom
You've been out wandering in the fields and forests and have found some fascinating fungi! You don't know what they are but want to find out more. How do you...
How to identify a mushroom
You've been out wandering in the fields and forests and have found some fascinating fungi! You don't know what they are but want to find out more. How do you...

Setting up an outdoor mushroom bed
Introduction Setting up an outdoor mushroom bed or companion planting with fungi can be a rewarding and fruitful endeavor. With a little mahi and luck you will have delicious edible...
Setting up an outdoor mushroom bed
Introduction Setting up an outdoor mushroom bed or companion planting with fungi can be a rewarding and fruitful endeavor. With a little mahi and luck you will have delicious edible...
General information
Mushroom Growing 101: Back when I first started growing mushrooms in early 2010 the information available was hard to find and often full of mistakes, conflicting information or just plain...
General information
Mushroom Growing 101: Back when I first started growing mushrooms in early 2010 the information available was hard to find and often full of mistakes, conflicting information or just plain...

How to Grow Mushrooms on Logs in Aotearoa New Z...
How to Grow Mushrooms on Logs in Aotearoa New Zealand Species Covered: Pleurotus pulmonarius (Phoenix Oyster), Hericium novae-zealandiae(Pekepeke-kiore), Cyclocybe parasitica (Tawaka) This guide outlines techniques for cultivating three edible fungi...
How to Grow Mushrooms on Logs in Aotearoa New Z...
How to Grow Mushrooms on Logs in Aotearoa New Zealand Species Covered: Pleurotus pulmonarius (Phoenix Oyster), Hericium novae-zealandiae(Pekepeke-kiore), Cyclocybe parasitica (Tawaka) This guide outlines techniques for cultivating three edible fungi...


Growing mushrooms on straw
Are you looking to dip your toes into the world of mushroom cultivation? Growing edible mushrooms on straw might just be the perfect first step for beginners. Straw is readily...
Growing mushrooms on straw
Are you looking to dip your toes into the world of mushroom cultivation? Growing edible mushrooms on straw might just be the perfect first step for beginners. Straw is readily...
Events
-
EcoFest 2025: All About Phoenix Oyster Mushroom...
All About Phoenix Oyster Mushrooms! When: 2:15 pm - 3:45 pm, 22nd of March 2025 Where: Kaipatiki Project 17 Lauderdale Road Auckland, Auckland 0626 Come join us at the Kaipatiki...
EcoFest 2025: All About Phoenix Oyster Mushroom...
All About Phoenix Oyster Mushrooms! When: 2:15 pm - 3:45 pm, 22nd of March 2025 Where: Kaipatiki Project 17 Lauderdale Road Auckland, Auckland 0626 Come join us at the Kaipatiki...
-
EcoFest - Grow Mushrooms with The Mushroom Smith
About this Event Sun 14th April 11:00 am to 12:30 pm Add to Google Agenda | Ical Export Location Auckland Botanic Gardens 102 Hill Road, Manurewa Auckland Head on down...
EcoFest - Grow Mushrooms with The Mushroom Smith
About this Event Sun 14th April 11:00 am to 12:30 pm Add to Google Agenda | Ical Export Location Auckland Botanic Gardens 102 Hill Road, Manurewa Auckland Head on down...